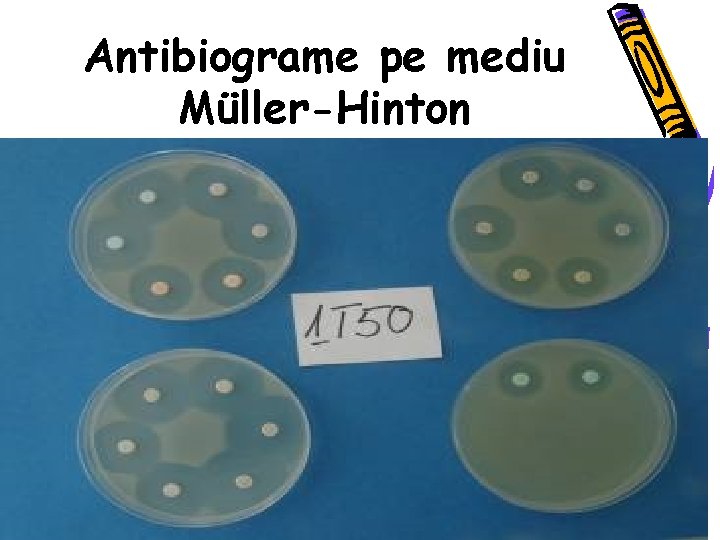
Antibiograme pe mediu Müller-Hinton
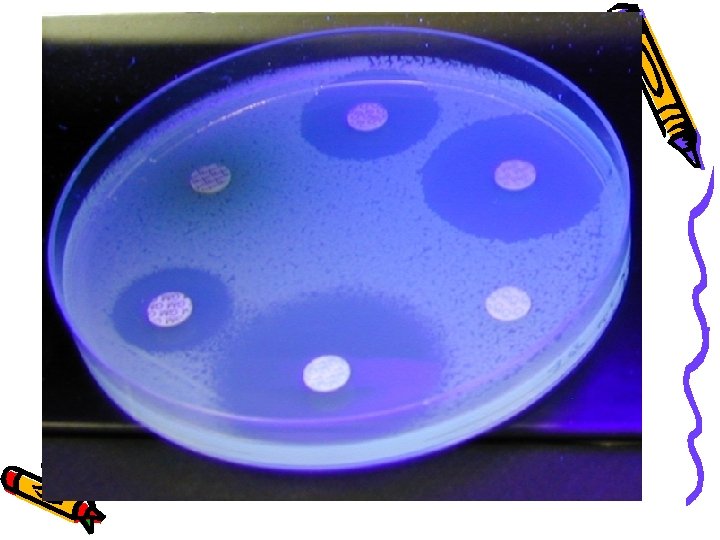
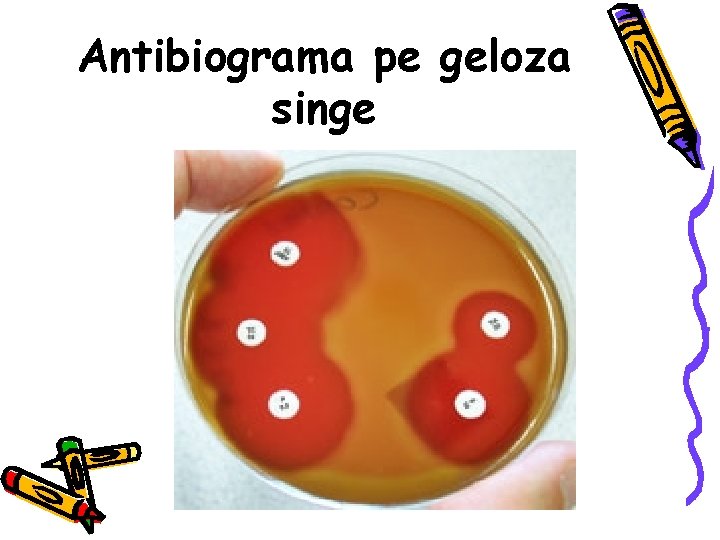
Antibiograma pe geloza singe
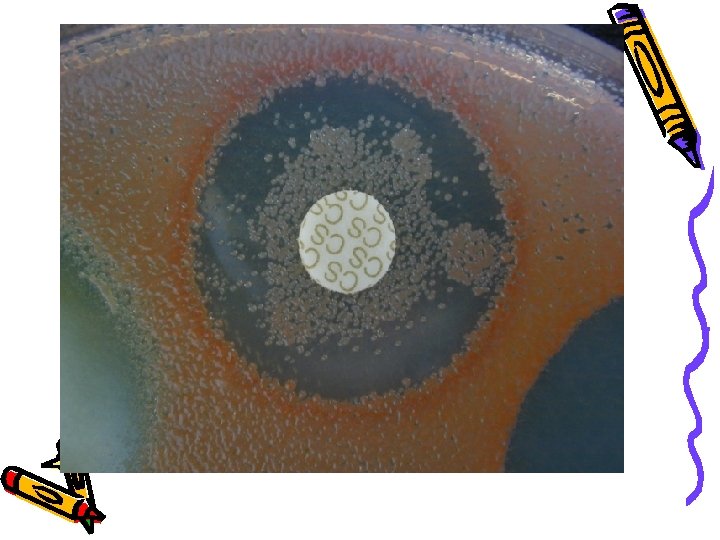
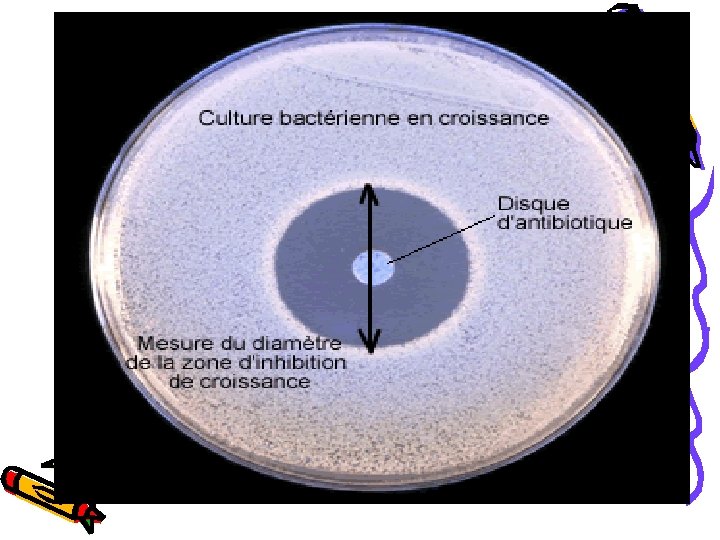
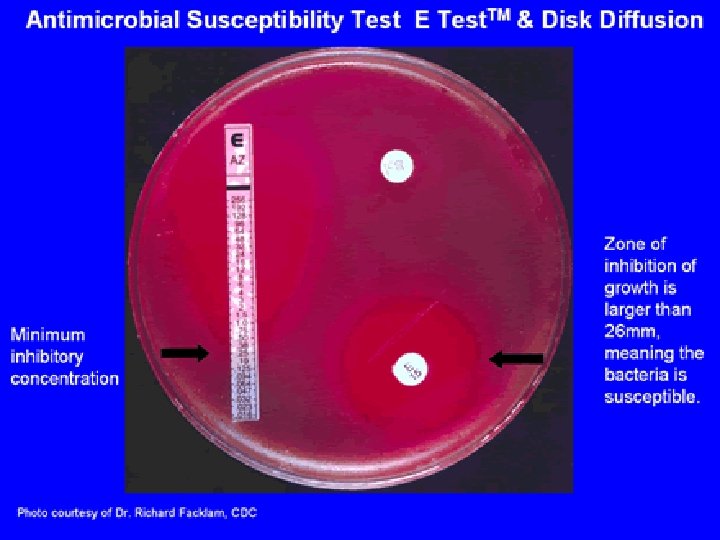

ANTIBIOGRAMA Tipuri de antibiograme DEFINITIE Prin antibiograma se

ANTIBIOGRAMA Tipuri de antibiograme

DEFINITIE • Prin antibiograma se intelege testarea sensibilitatii unei tulpini bacteriene izolate dintr-un produs patologic fata de diverse antibiotice. • Astfel se caracterizeaza capacitatea acestora de a opri dezvoltarea microbiana si da informatii pentru selectarea celui sau celor mai active antibiotice fata de microorganismul testat.

• Termenii de antibiotic si chimioterapic se folosesc ca sinonimi. • Introducerea unui antibiotic in terapie este o mare responsabilitate medicala, cerind respectarea unor conditii bine determinate:

1. Antibiograma se face dupa stabilirea diagnosticului etiologic, prin izolarea in cultura pura si prin identificarea agentului patogen. In cazuri de extrema urgenta, se poate administra un antibiotic (inainte de efectuarea antibiogramei) dar numai dupa recoltarea produselor patologice.

2. Tratamentul se realizeaza in functie de rezultatele date de antibiograma, alegind antibioticul cel mai eficace, adica fata de care bacteria izolata are cea mai mare sensibilitate.

3. Antibiograma trebuie repetata daca tratamentul cu antibiotice este de durata mai lunga; aceasta deoarece agentul patogen poate sa cistige rezistenta fata de antibioticul utilizat. Apoi in cursul tratamentului datorita dezechilibrului din populatiile microbiocenozelor, poate sa se produca o infectie supraadaugata cu o bacterie din aceste microbiocenoze.

• Principiul antibiogramei consta in capacitatea antibioticelor de a impiedica multiplicarea bacteriana, fenomen cunoscut ca efect bacteriostatic. • Unele antibiotice au in anumite concentratii si proprietatea de a omori bacteriile: efect bactericid.

Metode folosite pentru testarea sensibilitatii in vitro la antibiotice metode calitative – metoda difuzimetrica Kirby Bauer - clasica – metoda cu antibiotic incorporat in mediu semisolid – kit-ul comercial ATB Biomerieux, Franta - moderna • metode cantitative – metoda dilutiilor in mediu lichid - clasica – metoda Etest – AB BIODISK , Suedia – moderna

Metoda difuzimetrica(Kirby-Bauer) • Aceasta se efectueaza pe medii solide, in placi Petri, pe care s-a insamintat in pinza cultura bacteriana; apoi pe suprafata mediului se dispun discuri cu antibiotice astfel ca in jurul acestora se va realiza un gradient de concentratie prin difuziunea locala a antibioticului ( in imediata vecinatate a discului realizindu-se o concentratie mai mare de antibiotic care descreste pe masura indepartarii de acesta ).

Metoda difuzimetrica(Kirby-Bauer) • Metoda difuzimetrica, cu toate ca nu stabileste concentratia minima infibitorie (CMI), da informatii pretioase asupra sensibilitatii speciei testate fata de antibioticele utilizate si este folosita mai frecvent in laboratorele clinice.

Tehnica de lucru • Mediul de cultura indicat este geloza Müller-Hinton deoarece are o valoare nutritiva care permite dezvoltarea optima a unei mari varietati de bacterii si nu contine inhibitori ai actiunii unor antibiotice. • Pentru bacterii cu necesitati de cultura speciale, se utilizeaza medii adecvate ( de ex. pentru Streptococcus pyogenes se foloseste geloza singe ).

Tehnica de lucru • Coloniile izolate (5 colonii) obtinute din produsul patologic, se insaminteaza in bulion, care se incubeaza la 37 °C ( ~ 5 -10 min. ), se determina turbiditatea culturii corespunzatoare etalonului 0, 5 Mc. Farland ( cu ajutorul scarii. Mc. Farland cu sulfat de bariu sau automat pe densitometru ).

Tehnica de lucru • Se insaminteaza placile in maxim 15 min. de la etalonare ; se lasa placa insamintata 3 -5 min. (niciodata mai mult de 15 min. ) pentru adsorbtia inoculului. • Se depun discurile cu substante antibicrobiene la distanta de minimum 15 mm de marginea placii si 30 mm intre centrele a doua discuri vecine folosind o pensa sau, mai bine un dispersor automat de discuri.

Tehnica de lucru • Se incubeaza placile la 37° C pentru 16 -18 ore. • Control de calitate : testeaza pe alta placa, in aceleasi conditii , tulpina de referinta adecvata.

Dispersor de discuri pentru antibiograme, tuburi cu discuri impregnate cu antibiotice in diferite concentratii, placa cu agar Müller-Hinton pentru realizarea antibiogramei difuzimetrice

Citirea si interpretarea • Se masoara cu sublerul sau cu rigla gradata in mm , diametrul zonelor de inhibitie completa , in lumina reflectata, pe fond negru mat. • In cazul mediilor transparente se masoara pe spatele placilor, iar in cazul mediilor cu singe pe suprafata agarului.

Antibiograme pe mediu Müller-Hinton

Antibiograma pe geloza singe

• Aspectul Zonei de Inhibitie trebuie sa fie clar si cu contur net. • In situatia in care se observa chiar si o singura colonie in interiorul zonei de inhibitie, se va considera rezistenta la acel antibiotic, indiferent de diametrul zonei de inhibitie (vezi figura )

• In caz de urgenta , se poate citi antibiograma dupa 5 -6 ore de incubare, cu conditia verificarii diametrelor si la 16 -18 ore. • Se verifica daca diametrele zonelor de inhibitie ale fiecarei substante antimicrobiene sint cuprinse in limitele variatiei admise conform tabelelor de interpretare furnizate impreuna cu discurile.

INTERPRETARE • Se interpreteaza astfel : Sensibil S • Intermediar I • Rezistent R • in functie de valorile din tabelele de interpretare.


Metoda cu antibiotic incorporat in mediu semisolid – kit-ul comercial ATB Biomerieux, Franta • Principiu • Galeria ATB permite determinarea sensibilităţii microbiene la un set de agenti antibacterieni / antifungici , incorporate într-un mediu semisolid. Este alcătuită din 16 perechi de godeuri, din care 2/4 nu conţin antibiotice/antifungice şi sunt martori de creştere. • Celelalte perechi de godeuri conţin diferite antibiotice în cite două concentraţii (c = concentratie mai mica şi C = concentratie mai mare) pentru a putea eticheta fiecare tulpină testată ca fiind sensibilă, intermediară sau rezistentă.

Metoda cu antibiotic incorporat in mediu semisolid – kit-ul comercial ATB Biomerieux, Franta - Din tulpina de testat este preparată o suspensie care este transferată în mediul de cultură cu care este inoculată galeria ATB. - Rezultatele se citesc vizual sau automat dupa 2448 ore de incubare la 37 C. • Citire si Interpretare - Dacă nu există creştere la nici o concentraţie înseamnă tulpină sensibilă, daca exista creştere numai în godeul cu concentraţia mai mică c înseamnă sensibilitate intermediară, daca exista creştere în ambele godeuri (c şi C) semnifică rezistenţă la respectivul agent antimicrobian.


E-Test • E -Testul imbina acuratetea testarii cantitative si simplitatea testarii difuzimetrice cu mare economie de timp. • Pe suprafata unei langhete/bandelete de 5 mm/50 mm din plastic inert, neporos, este fixat un gradient exponential de antibiotic , desicat si stabilizat, cu 15 dilutii intre 0, 016 si 256 µg/ml sau 0, 002 si 32 µg/ml, iar pe cealalta suprafata este marcata scala de lectura in µg/ml corespunzatoare CMI.

E-Test • Pe suprafata unei placi cu mediu agarizat preinsamintata cu tulpina testata in conditii standardizate sint depuse radiar langhetele/bandeletele cu antibiotic. Dupa incubare corespunzatoare, CMI este indicata de intersectia dintre zona eliptica de inhibitie a culturii si scala de gradiente a langhetei

E-Test • Desi scump, testul este fiabil, reproductibil si permite determinarea concomitenta, pe aceeasi placa, a CMI ale mai multor antibiotice pentru bacterii aerobe sau anaerobe, supravegherea pacientilor pe parcursul terapiei antimicrobiene pentru a surprinde selectarea de clone rezistente ( ex. fata de ampicilina in meningitele determinate de H. influenzae, testarea pneumococilor fata de β -lactamine, a enterococilor fata de aminoglicozide cu depistarea rezistentei cu nivel inalt, a enterobacteriaceelor producatoare de βlactamaze cu spectru extins ).

Metoda dilutiilor in medii lichide • Aceasta urmareste determinarea limitei de sensibilitate a germenului fata de substanta data, indicind concentratia de chimioterapice sau antibiotice necesara pentru inhibarea dezvoltarii sale. In acest fel se determina ceea ce se cunoaste sub denumirea de concentratie minima inhibitorie ( CMI ).

Tehnica de lucru • In dilutii crescinde de chimioterapice si antibiotice facute direct din mediul de cultura lichid se insaminteaza cantitati egale din cultura de cercetat, stabilindu-se dilutia maxima a substantelor in prezenta careia tulpina este inhibata. • Pentru fiecare antibiotic se fac dilutii de pornire.

Tehnica de lucru • Concentratia initiala pentru penicilina este 100 UI/ml; cea pentru streptomicina de 100 µg/ml, pentru cloramfenicol 50 µg/ml, etc. Mediul de cultura utilizat este bulionul glucozat 2% preparat fara peptona daca se testeaza actiunea sulfamidelor.

Tehnica de lucru • Microorganismul testat se cultiva in bulion glucozat, iar din cultura de 18 -20 ore se face o dilutie de 1/100, care se insaminteaza in cantitati egale ( cite o picatura ) in toate dilutiile de antibiotic. • Pentru dilutii se utilizeaza 10 tuburi, fiecare se repartizeaza cite 1 ml bulion glucozat.

Tehnica de lucru • In primul tub se adauga 1 ml din solutia de antibiotic. Dupa omogenizare se trece 1 ml in al doilea tub si asa mai departe pina la tubul 9 de unde se indeparteaza 1 ml de solutie. Se insaminteaza tuburile cu cite o picatura din cultura testata. Tubul 10 este proba martor care serveste pentru controlul dezvoltarii tulpinii in mediul utilizat. • Citirea se face dupa o incubare la 37° C , timp de 18 -20 ore.

Citire si interpretare • Ultimul tub limpede indica limita sensibilitatii germenului, fata de substante sau concentratia minima inhibitorie activa ( CMI). Adaugind la mediu un indicator de ph ( rosu fenol ) se poate reduce timpul de citire a rezultatelor la 3 -6 ore intrucit virarea culorii mediului in urma modificarii ph-ului datorita dezvoltarii microbiene ( ph acid ) apare mai rapid decit tulburarea lui.

• Metoda dilutiilor succesive in mediu lichid • Citire si interpretare Dilutia din ultima eprubeta in care nu exista crestere bacteriana (mediul este limpede) reprezinta valoarea CMI. ½ ¼ 1/8 1/16 1/32 1/64 1/128 1/256 1/512

Discutii • Metoda dilutiilor in medii lichide este tehnica cea mai precisa de determinare a sensibilitatii microorganismelor la antibiotice si chimioterapice si in plus permite determinarea concentratiilor bacteriostatice si bactericide ale substantelor testate.

Discutii • Dozarea chimioterapicelor si antibioticelor din umorile organismului este necesara pentru evaluarea in vivo a eficientei unui tratament cu chimioterapice sau antibiotice. • Astfel se poate stabili daca concentratia substantei se mentine in umorile organismului la un nivel activ, permite controlul modului si ritmului de administrare , ajuta la aprecierea corespondentei intre eficacitatea in vivo si in vitro a substantei utilizate, etc.

Discutii • Aprecierea efectului bactericid prin metoda dilutiilor se realizeaza astfel: din ultimele 2 eprubete in care dezvoltarea a fost inhibata, se insaminteaza cu un inocul mic, tuburi cu mediu similar, dar fara antibiotic. • Lipsa dezvoltarii bacteriene in aceste tuburi indica efectul bactericid al antibioticului testat.

Concluzii • Antibiograma este una dintre cele mai utile determinari de laborator care aduce informatii pretioase privind atitudinea medicului in terapia cu antibiotice.

Concluzii • Antibiogramele se vor repeta ori de cite ori o dicteaza evolutia clinica dupa tratamentul cu antibiotice si eventual se vor utiliza asociatii de antibiotice pentru a obtine un efect terapeutic mai promt si prevenirea instalarii rezistentei bacteriei la antibiotice si chimioterapice.


VITEK 2 Compact Brings Rapid ID/AST Testing to Labs • The newest product by bio. Mérieux Inc, VITEK® 2 Compact, is expected to bring these advantages to small and mid-size laboratories. • Currently awaiting approval by the Food and Drug Administration (FDA), the VITEK 2 Compact uses the same technology as the VITEK 2 to deliver results the same day, but with a smaller footprint.

• The original VITEK was developed by the Mc. Donnell Douglas Corp of St. Louis, Mo, for the aerospace program, but its clinical applications were realized and developed by what became the VITEK subsidiary of the company. The product was sold to bio. Mérieux, a French company, in 1992, before Mc. Donnell Douglas’ merger with Boeing. • bio. Mérieux immediately set out to bring the product to the next level and introduced the VITEK 2 in 1998. The system was designed to introduce workflow efficiencies and sophistication for larger laboratories. In 2001, the company began development of the VITEK 2 Compact to offer the technology within a smaller unit.

How It Works • The VITEK 2 and VITEK 2 Compact use a standard inoculum to prepare an organism suspension and sophisticated algorithms to analyze parameters and test conditions. A variety of susceptibility cards used in the instruments are available to allow an institution to match the susceptibility testing to its pharmacy antibiotic formulary. • Each susceptibility card contains 64 small-volume wells, with representative antibiotics in each well. The optical system reads the wells every 15 minutes. • The new photometric technology in the instrument takes advantage of advances in optics to detect changes in growth for each well. The system also can identify an organism’s phenotype based on the antibiotic susceptibility through pattern recognition using the Advanced Expert System (AES).

• According to Donahoe, portions of the setup and process can be completed by a low-level technologist or technician, but validation requires a laboratory technologist, though not necessarily one specializing in microbiology. The AES helps with verification. “This software package puts a Ph. D-level review in the hands of the small lab, which typically lacks the scientist traditionally needed to run this test, ” Donahoe says. • The VITEK 2 Compact does not feature as much automation as the VITEK 2, but it does eliminate a number of manual steps, allowing consistent handling of the test process as well as time and cost savings. In addition, the expanded menu eliminates the need to run extra tests • Donahoe reports that the mean time for result delivery is 6 – 8 hours. “Roughly 80% of identification and susceptibility results are delivered in 6 hours, 90% within 8 hours, ” he says. “This means that nine of ten patients could have their results in 8 hours or less. ”
- Slides: 53